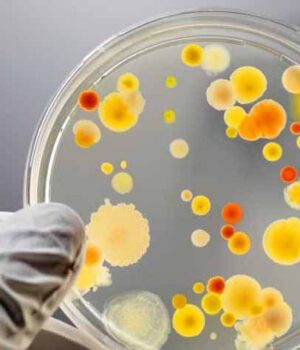
Класична відписка

Надійшла на мій інформаційний запит від во начальника Нововолинського управління Держпроспоживслужби Я.Ю. Лешка. На філію якого покладені обов’язки контролю за санітарно-епідеміологічною ситуацією у нашому місті. У ній він посилається на, нібито, відібрані у них законом України «Про основні засади нагляду (контролю) за господарською діяльністю» повноваження по перевірках і впливу на підприємців, що торгують чи виробляють харчову продукцію для населення і на державні та приватні заклади громадського харчування – стаття 6.
Проте, у тому ж законі, стаття 8 пункт 2, говориться, що таке право у них є і перевіряти всіх і все вони таки зобов’язані, якщо це загрожує життю і здоров’ю людей. Незрозуміло тільки, за що державні службовці Держпродспоживслужби отримують зарплати, премії і преференції у вигляді трудового стажу, і відповідно, й пенсії за кошти платників податків України.
Безумовно, що про цей чиновницький розгардіяш у Нововолинську, буде повідомлено у центральні органи Управління Держпродспоживслужби для притягнення винних до відповідальності за бездіяльність. У місті склалися напружені відносини між населенням і деякими приватними підприємствами – забруднювачами довкілля, що прямо чи опосередковано впливають на здоров’я і тривалість життя громадян та їхніх малолітніх дітей.
Нещодавно, для вирішення питань, щодо катастрофічного стану екології у найбільш густозаселених теренах міста, зокрема на 5, 6 і 15 мікрорайонах, було залучено народного депутата ВРУ Ігоря Гузя. То його просто, взяли і не пустили на приватне підприємство «Екопротеїн»! На збори мешканців, які організував і провів нардеп, представники місцевої влади – міський голова В.Сапожніков і його заступники не прийшли. Постійно підтруює, як вбачається, людей у тому ж районі і завод по виготовленню ДСП «Кроношпан-UA». Подейкують, що фільтри для вловлення парів формальдегідних смол, які застосовуються у виробництві продукції, а також викидів деревного пилу – як шкідливого похідного компоненту виробництва, там взагалі не встановлені через їхню високу вартість. Окрім того, у тому ж районі знаходяться асфальтовий завод, який орендує скандальний і максимально наближений до найвищих керівників органів місцевого самоврядування приватний підприємець та велика приватна ливарня. Напруження між мешканцями Нововолинська, через бездіяльність умовно контролюючих санітарну ситуацію у місті державних органів, та нереагування на ці події із боку місцевих владних чиновників, наростає.
23. 09. 2016 року
Анатоль Бідзюра, член територіальної громади, голова ГО «Україна + Польща»